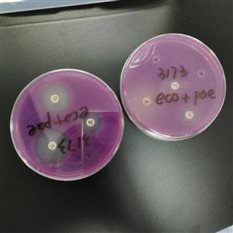
4334a7041b29b581098598bec730125 4334a7041b29b581098598bec730125

洋葱伯克霍尔德菌是院内感染的重要条件致病菌,通常对健康人体并不致病,多侵袭免疫力低下的个体,常定植于囊性纤维化和慢性肉芽肿患者的肺部,是一种高毒力病原菌。
生物学特性
洋葱伯克霍尔德菌是一种无芽孢革兰阴性,非发酵需氧菌,大部分分离菌株不产生色素,有粪臭味(如图1)。某些菌种有特殊的菌落形,特别的色素,特殊的气味。近日我科分离一株产色素洋葱伯克霍尔德菌,血平板可见黄紫色菌落(如图2),普通营养琼脂平板呈紫色(图4),同我们平时见到的洋葱(图3)颜色真的一样呀!洋葱伯克霍尔德菌的名称来源是否与此有关呢?
标本类型
洋葱伯克霍尔德菌广泛存在于土壤及水中,是医院常见病原菌之一,可从医院自来水,体温表,喷雾器等处分离到。也可从痰液,血液,穿插组织,脓液等临床标本中检测到。
感染人群
洋葱伯克霍尔德菌通过呼吸道传播,多侵袭免疫力低下,年龄大患者(为什么受伤害的总是我?)。
治疗方案
洋葱伯克霍尔德菌的治疗让医生感到头疼。该菌大部分菌株具有多重耐药性,多种药物天然耐药让临床医生感觉无药可用,临床治疗存在困难。根据美国临床和试验室标准化协会抗微生物药物敏感性试验标准推荐用药:替卡西林-克拉维酸,头孢他啶,美罗培南,米诺环素,左氧氟沙星,甲氧苄啶-磺胺甲恶唑,氯霉素。

鉴别诊断:虽然洋葱伯克霍尔德菌比较难治,但同一菌属的鼻疽伯克霍尔德菌和假鼻疽伯克霍尔德菌更可怕,后两种是生物恐怖菌,人类和动物之间相互传染。所以在工作中我们对这种菌的鉴定一定要注意。